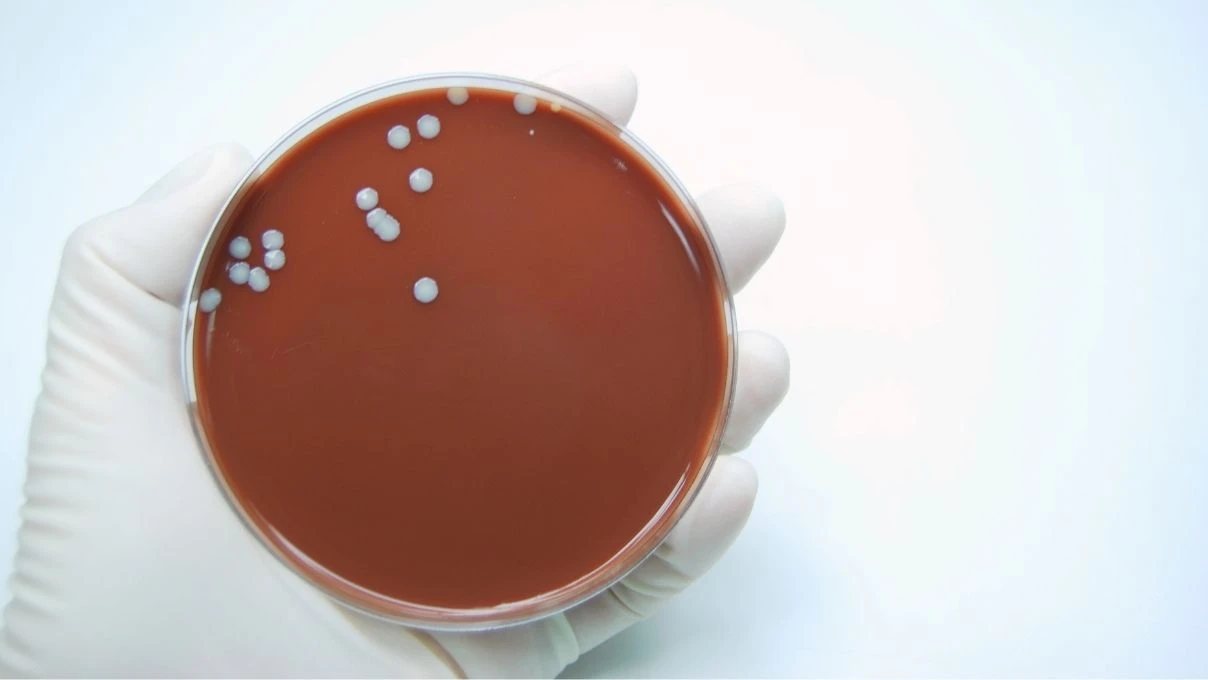
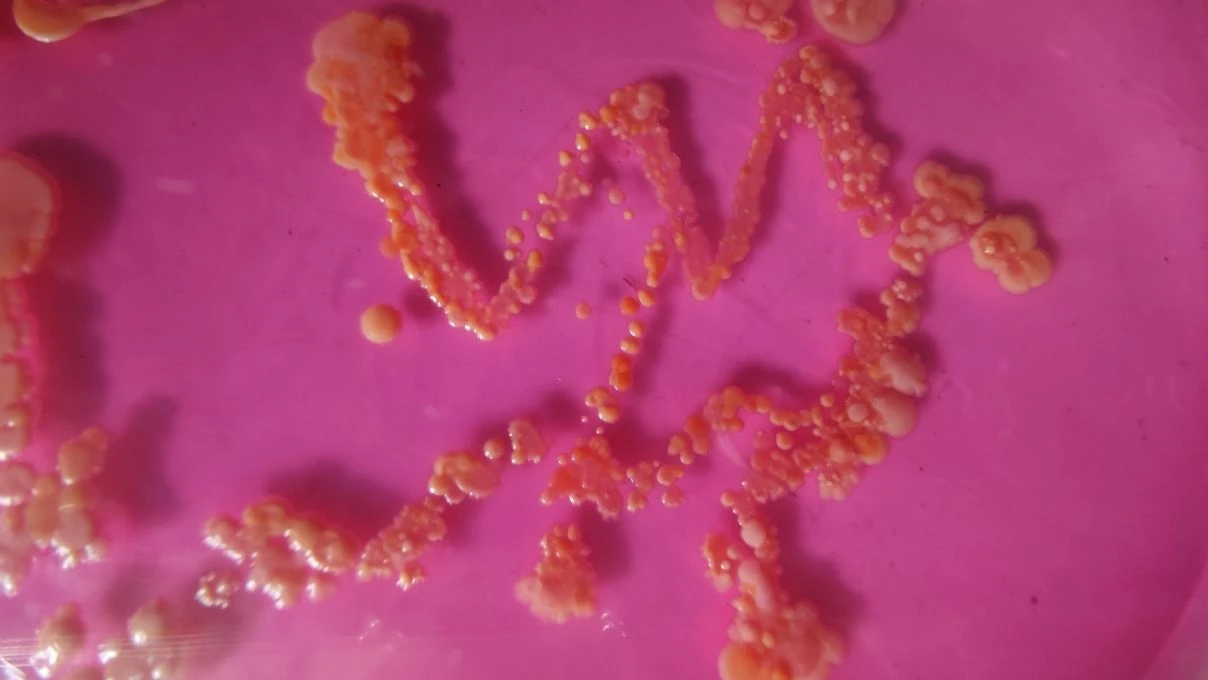

Market raflarında satılan hazır gıdalar halk sağlığını tetikliyor. Et v Süt Kurumu’nun dergisinde yayımlanana göre, hazır gıdalarda “staphylococcus aureus” bakterisinin olduğu tespit edildi. İşte detaylar…
Günlük hayatın telaşından bazen zaman bulunamıyor, Özellikle de bu zamansızlık mutfakta daha bir önem kazanıyor. Marketlerde satılan hazır gıdalar her zaman ilk tercih edilen yiyeceklerden biri oluyor. Ancak marketlerden alınan ürünleri artık tüketmeden önce iki kez düşünmelisiniz.

Et ve Süt Kurumu’nun dergisinde yayınlanan araştırmada görülen o ki zararlı maddeler ve insan sağlığını tehlike altına atıyor. Bundle’nin ve Milliyet’in haberine göre, Ankara’da yapılan farklı hipermarketlerde satılan ve tüketime hazır olan gıdalar incelendi.

Yapılan analizler de halk sağlığı açısından tehlikeli kabul edilen “staphylococcus aureus” bakterisinin, kullanılan birçok üründe olduğu tespit edilmiştir. Peki, nedir bu staphylococcus aureus? sizin için araştırdık.

Staphylococcus Aureus genellikle ciltte görülen yaygın bir bakteridir. Bu bakteriler ayrıca burun yollarına da herhangi bir problem göstermeden varlıklarını sürdürür. Staph, bir kesik yaradan cilde girdiğinde enfeksiyonlara neden olur.
Enfeksiyon, bakteriler bir kateter ya da solunum tüpü yoluyla vücudun içine girer. Enfekte olmuş deri gün geçtikçe kötüleşmeye başlar. Kan oluşumu meydana gelir. Zatürre ya da öksürük ve idrar yolu enfeksiyonunu gibi belirtiler staphylococcus aureus bakterisinin teşhisi arasında yer alır.

Bağışıklık sistemi zayıf kişiler, yaşlılar, küçük çocuklar, kronik hastalığı olanlar, sporcular ve kalabalık ortamda bulunan kişiler staphylococcus aureus bakterisinden en çok etkilenen kişiler arasında yer alır.
Marketlerde bulunan hazır gıdaların içerisinde bulunan bu bakteri araştırma kapsamında belli başlı gıdaların içerisinde çıkmıştır. Bu gıdalar ise günlük hayatta kullanılan ürünler arasında yer almaktadır.

Rus salatası, İtalyan salatası, tavuk salatası, kadınbudu köfte, Arnavut ciğeri, tavuk döner, kremalı yaş pasta, kazandibi ve keşkül gibi ürünlerden toplanan örnekler sonucu, Kadınbudu köfte, tavuk döner, tavuk salatası ve kazandibi gıdalarında yüzde beş staphylococcus aureus bakterisi tespit edilmiştir.

Arnavut ciğerinde yüzde on, keşkül örneklerinde yüzde on beş, kremalı yaş pastalarda ise yüzde yirmi oranında staphylococcus aureus bakterisi bulundu. Rus salatası ve İtalyan salatalarında bakteriler tespit edilmedi.